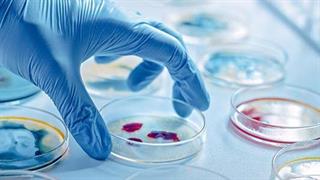
Covid-19: Ενθαρρυντικά αποτελέσματα από συνδυαστική θεραπεία in vitro

Τρίτη, 01 Δεκεμβρίου 2020, 12:20
Μήνυμα του Πρόεδρου του ΚΕΘΕΑ για την Παγκόσμια Ημέρα κατά του AIDS''H σημερινή Παγκόσμια Ημέρα κατά του AIDS αποκτά φέτος, εν μέσω της Πανδημίας ενός άλλου ιού, του SARS-CoV-2, ξεχωριστό νόημα'', δήλωσε ο Χρίστος Λιάπης.
Τρίτη, 01 Δεκεμβρίου 2020, 11:10
Ο κορωνοϊός μπορεί να φτάσει στον εγκέφαλο μέσω της μύτηςΝέα έρευνα αναφέρει ότι ο SARS-CoV-2 δεν επηρεάζει μόνο το αναπνευστικό αλλά και το ΚΝΣ οδηγώντας σε νευρολογικά συμπτώματα όπως απώλεια όσφρησης, γεύση,ς κούραση και ναυτία.
Δευτέρα, 30 Νοεμβρίου 2020, 12:17
Οι ασθενείς που νοσηλεύθηκαν με COVID-19 έχουν μεγαλύτερους τίτλους εξουδετερωτικών αντισωμάτων έναντι του SARS-CoV-2Δεδομένα από την Ελλάδα, έγιναν προσφάτως δεκτά για δημοσίευση στο διεθνές ελβετικό ιατρικό περιοδικό Microorganisms.
Τετάρτη, 25 Νοεμβρίου 2020, 18:12
Η λοίμωξη με τον SARS-CoV-2 σχετίζεται με αυξημένη επίπτωση ισχαιμικών αγγειακών εγκεφαλικών επεισοδίωνΟι συγγραφείς έδειξαν ότι από τους ασθενείς που ελέγχθηκαν θετικοί στον ιό SARS-CoV-2, το 1,3% εμφάνισε συννοσηρότητα και νοσηλεύτηκε για οποιασδήποτε αιτιολογίας ΑΕΕ, το 1.1% εμφάνισε ισχαιμικό ΑΕΕ και το 0.2% εμφάνισε αιμορραγικό ΑΕΕ.
Τρίτη, 24 Νοεμβρίου 2020, 12:56
Ηθικές και επιστημονικές θεωρήσεις σχετικά με την πρώιμη έγκριση και ευρεία διάθεση εμβολίων κατά του SARS-CoV-2Η διασφάλιση της επιστημονικής εγκυρότητας και της κοινωνικής αξίας των εμβολίων πρέπει να συνεχίσει να αποτελεί προτεραιότητα.
Δευτέρα, 23 Νοεμβρίου 2020, 14:35
Η χρήση κορτικοστεροειδών σε ασθενείς με σοβαρή COVID-19 και σύνδρομο οξείας αναπνευστικής δυσχέρειαςΗ χρήση των κορτικοστεροειδών στην αντιμετώπιση της σοβαρής πνευμονίας από τον ιό SARS-CoV-2 αποτελεί καθημερινή πρακτική.
Δευτέρα, 23 Νοεμβρίου 2020, 13:03
Μεθοδολογίες για την ανίχνευση του SARS-CoV-2 στα λύματαΕργασία, που δημοσιεύτηκε από την διεπιστημονική ομάδα του ΕΚΠΑ.
Πέμπτη, 19 Νοεμβρίου 2020, 17:28
Ευρεία σύσκεψη του ΙΣΑ και της Περιφέρειας Αττικής με τους εκπροσώπους των Συλλόγων Ασθενών για την πανδημίαΤονίστηκε η ανάγκη να ενισχυθεί η ΠΦΥ για να καλυφθεί το κόστος του μοριακού ελέγχου για SARS-CoV-2, για όλους τους πολίτες.
Τρίτη, 17 Νοεμβρίου 2020, 20:07
Covid-19: Ενθαρρυντικά αποτελέσματα από συνδυαστική θεραπεία in vitroΣτο εργαστήριο, συνδυασμός remdesivir και hrsACE2 μείωσε το ιικό φορτίο sars-cov-2 και κατέστειλε τον πολλαπλασιασμό του ιού σε κυτταρικές καλλιέργειες.
Δευτέρα, 16 Νοεμβρίου 2020, 12:21
Πάνω από τους μισούς ασθενείς που διαγιγνώσκονται θετικοί για τον SARS-CoV-2 και είναι ασυμπτωματικοί τη στιγμή της εξέτασης δεν αναπτύσσουν συμπτώματαOι ασυμπτωματικοί ασθενείς κατά τη στιγμή της διάγνωσης του SARS-CoV-2 έχουν σημαντικές πιθανότητες να μην εμφανίσουν συμπτώματα της λοίμωξης, ενώ μεταδίδουν τον ιό κατά τη διάρκεια της θετικότητός τους.

Χρόνια νεφρική νόσος: Τι πρέπει να γνωρίζουμε
Χρόνια νεφρική νόσος: Τι πρέπει να γνωρίζουμε Πώς θα προλάβουμε τον διαβήτη
Πώς θα προλάβουμε τον διαβήτη Αλκοόλ και αντικαταθλιπτικά: Γιατί δεν πρέπει να τα συνδυάζουμε
Αλκοόλ και αντικαταθλιπτικά: Γιατί δεν πρέπει να τα συνδυάζουμε Μικροβιακή αντοχή: Μία πανδημία σε αργή κίνηση που μπορούμε να αποτρέψουμε
Μικροβιακή αντοχή: Μία πανδημία σε αργή κίνηση που μπορούμε να αποτρέψουμε